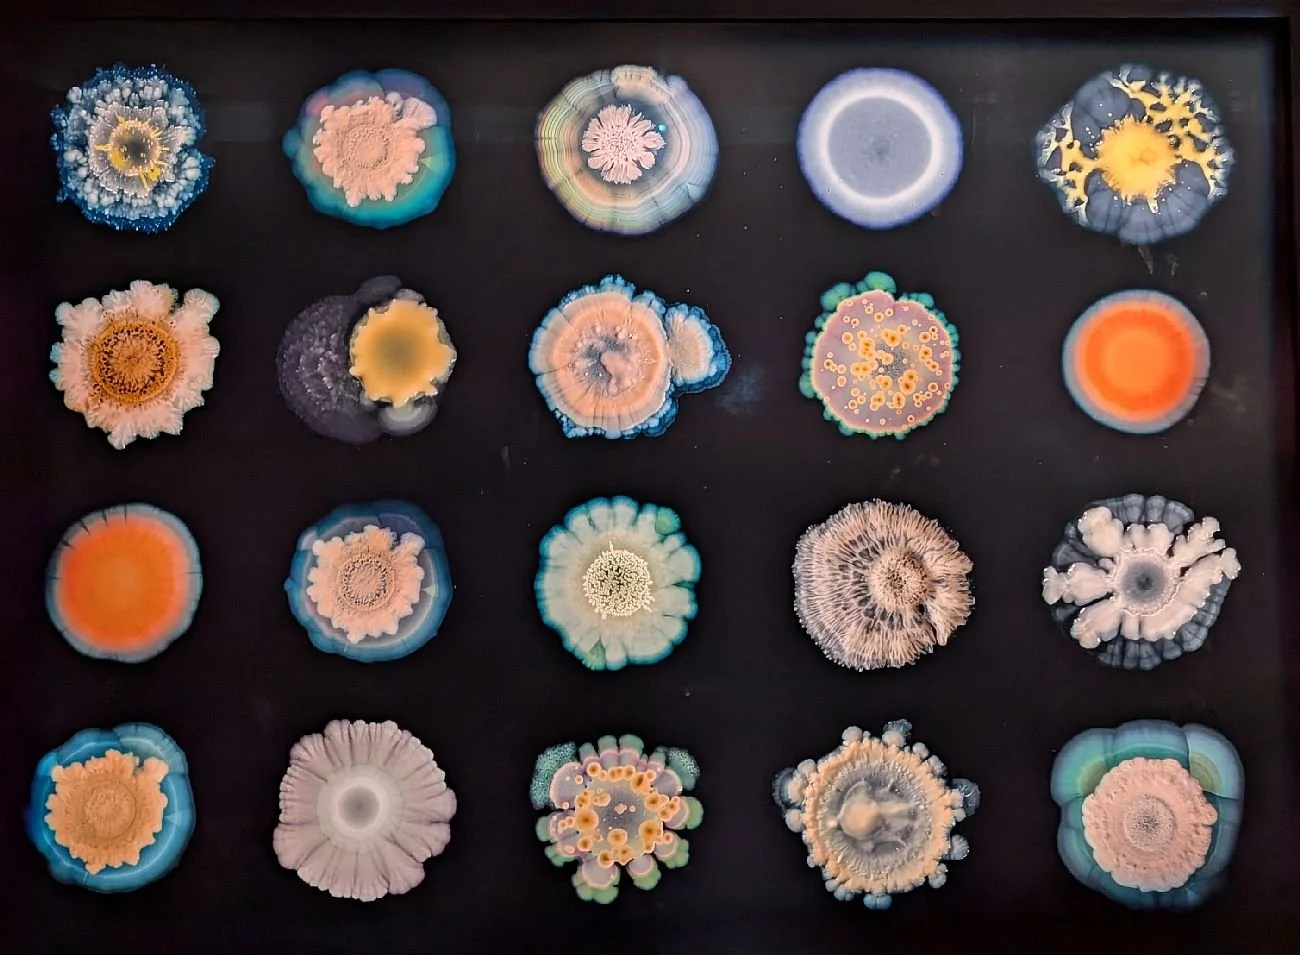

Science, Art or Crusade?
No, let’s step back a bit before we answer that question.
Terroir had heard good things about the exhibition entitled ‘Soil’ at London’s Somerset House. As much as anything, we were intrigued to know how such a display would be mounted and what story it would tell. Everyone else we mentioned it to seemed more surprised by the topic, than intrigued, and few seemed enthusiastic to attend. https://www.somersethouse.org.uk/whats-on/soil
Perhaps they were right, because both finding the ticket desk and navigating the exhibition was a bit of a challenge. By the time this blog is posted, the exhibition will be open for only three more days so here are some time-saving tips for a last minute visit. First of all, read the website (we didn’t) and enter Somerset House by the Embankment entrance, not from the Strand. This will save you having to traipse across the internal courtyard, although that also means you will miss the lines of intriguing fabrics, billowing in the quad’s breezy micro-climate (more of that in a future blog, we hope). Even if entering from Embankment you may still need to enquire as to the location of the ticket desk as it is in the basement (sorry, at lower ground floor level), presumably surrounded by subsoil.
So you have your tickets and are directed to the exhibition portal (‘door’ seemed too ordinary a description) to start your exploration of ‘Soil’. Again, if we had read the website, we would have known that “This exhibition has low level lighting”. We would not have known, however, that this exhibition can also be ‘Quite difficult to navigate’ in other ways as well!
For example, questions such as ‘am I allowed in there?’, ‘where do I go next?’ and ‘is that space private or part of the exhibition’ may also need to be answered. Perhaps all this is part of the mystery of ‘Soil’. Alternatively, it may be due to a lack of helpful signage or to mounting an exhibition in a very awkward space - you decide. You may also have better eyesight than us or just be generally more appreciative of, or sympathetic to, confusing layouts!
The first thing you see on entering the magic land of ‘Soil’ is a short definition of what ‘soil’ actually is, in a physical/chemical/biological sense. To one of us (who had studied soils twice during a total of four years in academe), it was very familiar and rather a let-down. One of us had come to the exhibition to be intrigued, enlightened and inspired, not read a first year undergraduate introduction to the definition of soil. And I don’t think one of us was being over-picky. The first thing you should see or read in any exhibition, book or article should be the ‘hook’ or the thing that will draw you in and excite you to delve further.
The second thing you see does not, in our view, do much better (right and below)! Sure, this ‘Look Down’ message is very important but does it sound a tad condescending to you? Again, it failed to hook one of us in. If you paid £18.50 for a ticket (£15.00 concessions/Child 6-11 £10.00) then I suggest that this ‘public-open-space-interpretation-board’ style of writing could be viewed as, hmm, slightly pedestrian (excuse the pun), considering what comes next. Is this blogger ever satisfied?
But what does come next? Science, art and, finally, the ‘hook’ is what comes next. Let the magic begin!
Diversity of Forms 2020 – Photographic Images of bacterial growth on agar plates Dr Tim Cockerill in collaboration with Dr Elze Hesse
“Bacteria taken from a combination of metal-contaminated soils in Cornwall and ordinary potting compost” Exhibition catalogue.
Of course, our inner scientist wanted to know what these bacteria might have looked like without the contamination. Yeah, yeah, some of us are never satisfied! And, ironically we had to ‘look’ up to get a better view of this particular exhibit. Crane your necks, kids!
The first big thrill for us was a couple of time lapse videos, one of activity within a soil and the other of a Fly Agaric toadstool dispersing spores. We have only reproduced still images here but, believe us, these were mesmerising.
Moving on (somewhat relucantly) we suspect that the images below will be especially attractive for children …
… although we will never again look at our favourite teddy bear (left) in quite the same light.
Frances Bourély - electron microscope images of soil flora
For art, beauty and interaction with soil and nature try these:
And now to roots music: Blue Stem - Jim Richardson
“The vast majority of prairie grass plants exist underground, out of our site. Growing downwards, up to four metres, they contribute to soil health and biodiversity, preventing erosion and storing carbon.” Exhibition catalogue
We forgot to include history and pre-history in our blog title. The role of soil in archaeology is, of course, crucial, but is something we tend to forget.
Above left: Joana Hadjithomas and Khalil Joreige - Trilogies: Monastiraki Athens, “the material imprint left by both human actions and natural events can produce varying historical narratives while acting as scientific markers of time” Exhibition catalogue.
Above centre and right: Cambridge Archeaological Unit - Iron Age Sword. Excavated from the fens, this armament was perfectly preserved in waterlogged silt. Yes, that wooden grip is original.
For an ecological ‘wilderness’ challenge we were intrigued by Mike Perry’s ‘Reverse Sod Swap’, pictured below.
In 1983, artist David Nash swapped a circle of pristine London lawn (containing just three species) for a circle of rough turf from North Wales with 27 species. In 2004, Mike Perry reversed the process (pictured above) using ‘wilded’ turf from Springfield Park in Hackney for a piece of sheep-grazed turf from West Wales. The species count was very revealing: 39 species in the urban turf and only four in the rural turf. Mike Perry: “I wanted to challenge the idea of ‘wildness’ as something only found in the countryside, when in fact our rural environments are fast becoming worn-out industrial landscapes”. Exhibition Catalogue.
Have you ever looked out of an aircraft window onto a semi arid landscape and noticed the circular patterns of the irrigation system below? That was a tough sentence to type, encapsulating as it does the need to be in an aircraft and the possible soil and water degradation which creates this 21st century ‘land art’ vision.
All this flashed through our minds as we caught site of Asunción Molinos Gordo’s work ‘Ghost Agriculture’ hanging on a far wall. “The geometry of the Nile valley discloses an encrypted dispute over natural, human and economic resources. … a crochet of thousands of small rectangular plots of land, none bigger than 100 square metres and each irrigated by renewable Nile water [producing] food to supply national demand. … Zooming out into the desert large circles appear … irrigated with non-renewable fossil water … [producing] commodities for export”. This dichotomy is superbly illustrated by the patchworks illustrated below. They are embroidered on Egyptian cotton: we hope this is a local, home grown fabric, not a product of the larger, private company/government combos on the desert plots.
Our final offering from this extraordinary exhibition is perhaps one of the most poignant. Annalee Davis’s ‘Saccharum officinarum and Queen Anne’s Lace’ portrays the plantation life of enslaved people in Barbados: the men tending the sugar cane and the women “rulers of the domestic space” creating embroidery and crockery for the home.
The art work is created on a plantation paylist document, symbolising the men’s role in the ‘capitalist machinery’ of the plantation and represented by the faceless rigid lines and columns. The role of the women is illustarted with ‘meandering crochet’ which interupts the document’s symetry and represents the ‘unpaid labour, knowledge and cultural inheritance’ of the women. Whichever way you read it, it is a a deeply moving comment on the impact of plantations and enslavement and the soils which supported this economy.
So, from grumpy ‘where is this exhibition’ to unexpected appreciation of a stimulating, varied and disturbing set of presentations. Science, Art or Crusade? Yes to all, if you are willing to look for it.
We hope you have already seen ‘Soil’ or can go before the show closes. Let us know what you think. We have had to miss out so many of the exhibits and we hope you disagree with us on many things. if nothing else, this exhibition should stimulate debate.